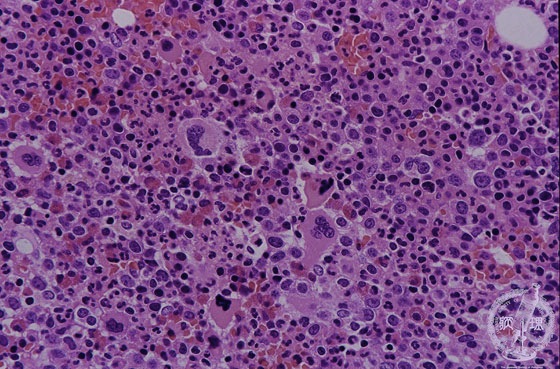

- 1.Bone marrow / Hematopoietic system
- ★(6) Myeloproliferative disorders (Primary myelofibrosis)
Microscopic image (H&E high power view): In the marrow granulocytic and megakaryocytic precursors proliferate as well as the erythroid progenitors. However, the blast cells do not proliferate. Thrombocytosis and granulocytosis are often accompanied. Polythythemia vera, one of the myeloproliferative disorders, transforms to primary myelofibrosis. The picture of the marrow resembles that of chronic myeloid leukemia, however microscopic features of peripheral blood smear are different.
Click the image to see the enlarged image.













